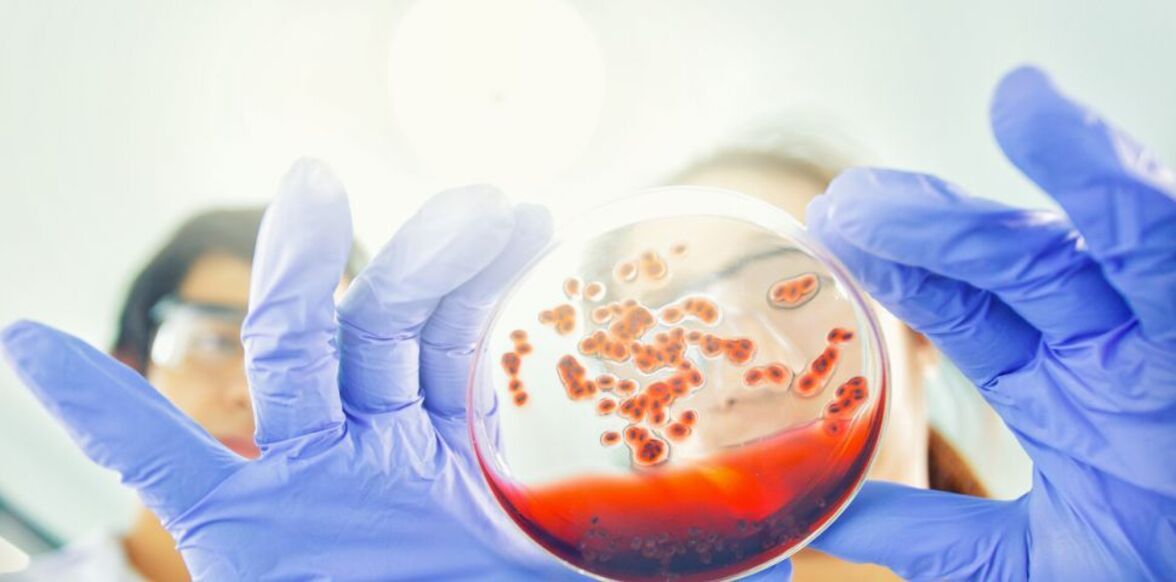
Sidhartha R. Sinha et al.  Дисбиоз-индуцированный вторичный дефицит желчной кислоты способствует развитию воспаления кишечника.

Ученые обнаружили семейство микробов, которые у некоторых людей отсутствуют, что может объяснить язвенный колит.
Группа ученых из Stanford University School of Medicine, Калифорния, обнаружила кишечный микроб, отсутствующий у некоторых людей. Это открытие может быть ключом к пониманию того, почему у некоторых людей развивается язвенный колит.
Ученые надеются, что, заменив функцию этого пропавшего микроба, можно будет разработать новые и более эффективные методы лечения язвенного колита.
Национальный институт диабета и болезней пищеварительной системы и почек отмечает, что язвенный колит является одним из видов воспалительных заболеваний кишечника.
Оно вызывает воспаление и язвы в толстой кишке человека, что может привести к болям в животе, потере веса, диарее, содержащей гной или кровь, и другим проблемам.
Симптомы язвенного колита могут варьироваться от легких до тяжелых, и в настоящее время нет никакого лечения. Вместо этого лечение направлено на то, чтобы как можно дольше держать болезнь в ремиссии.
Лечение обычно начинается с медикаментов, но если они не помогают, может потребоваться операция.
По данным Американского Фонда Крона и Колита, 23-45% людей, страдающих язвенным колитом, в конечном итоге должны будут пройти операцию.
Операция заключается в полном удалении толстой кишки и прямой кишки. После этого хирург создаст либо стому, которая будет действовать как внешний мешочек для сбора содержимого кишечника, либо илеоанальный резервуар, который представляет собой J-образный мешочек на конце тонкого кишечника, выполняющий ту же самую работу.
До сих пор ученые не были уверены, почему язвенный колит поражает одних людей, а не других. Новые исследования, проведенные группой из Стэнфорда, позволяют предположить, что ключевой причиной может быть отсутствие конкретных микробов кишечника.
Некоторые люди, которым сделали операцию по созданию J-образного мешочка при язвенном колите, затем обнаруживают, что воспаление и связанные с ним симптомы возвращаются.
Интересно, что люди, имеющие генетическое состояние семейного аденоматозного полипоза (FAP), который также требует создания J-образного мешочка, никогда не испытывают никаких воспалительных симптомов.
Исследователи хотели выяснить, почему это так. Для этого они сравнили две группы участников, одна с FAP и другая с язвенным колитом, ища любые значительные различия между ними.
Они обнаружили, что ключевым отличием было наличие типа желчной кислоты в кишечнике, который был в гораздо больших количествах в тех, с FAP, чем в тех, с язвенным колитом.
Эти желчные кислоты являются естественной частью здорового кишечника и помогают расщеплять жиры.
В кишечнике бактерии преобразуют эти желчные кислоты во вторичные.
Ученым удалось идентифицировать специфическое семейство бактерий под названием Ruminococcaceae, которые были недостаточно представлены в тех, у кого язвенный колит.
Бактерии Ruminococcaceae являются основным типом микробов, которые преобразуют первичные желчные кислоты во вторичные желчные кислоты.
Как отмечает доктор Аида Хабтезион, доцент и старший автор исследования: "У всех здоровых людей в кишечнике есть Ruminococcaceae". Но у пациентов с язвенным колитом члены этой семьи значительно истощены".
Помогая подтвердить свои выводы, исследователи обнаружили, что образцы стула у участников с ФАП превратили первичные желчные кислоты во вторичные, в то время как образцы с язвенным колитом - нет.
Затем группа дала добавки с кислотой мышам, у которых был язвенный колит, чтобы заменить недостающие вторичные желчные кислоты. Это уменьшило воспаление, а также нормальные симптомы колитов у мышей.
"Это исследование помогает нам лучше понять болезнь", - говорит доктор Хабтезион.
Для достижения этой цели команда в настоящее время проводит клиническое исследование, чтобы выяснить, может ли добавка кислоты помочь людям, страдающим язвенным колитом.